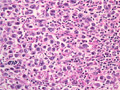

- 16.Male genital organs
- ★(4)Seminoma (Germ cell tumor)
Macroscopic appearance: Seminoma. Soft and well marginated pale to yellow tumor with bulging cut surface (yellow dotted line). Unless other types of germ cell tumors coexist, hemorrhage or necrosis is rarely found.
Click the image to see the enlarged image.